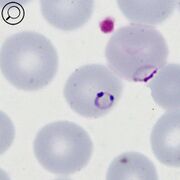

File list
This special page shows all uploaded files.
| Date | Name | Thumbnail | Size | User | Description | Versions |
|---|---|---|---|---|---|---|
| 19:29, 14 February 2025 | 13 Mess & troph.jpg (file) |  |
60 KB | Admin | 1 | |
| 19:26, 14 February 2025 | 12 Mess & troph.jpg (file) |  |
60 KB | Admin | 1 | |
| 19:26, 14 February 2025 | 12 Mess & troph anno.jpg (file) |  |
61 KB | Admin | 1 | |
| 19:10, 14 February 2025 | 11 Mess only - anno.jpg (file) |  |
67 KB | Admin | 1 | |
| 19:09, 14 February 2025 | 11 Mess only.jpg (file) |  |
61 KB | Admin | 1 | |
| 10:53, 11 February 2025 | 3 Trophs HP.jpg (file) |  |
37 KB | Admin | 1 | |
| 10:53, 11 February 2025 | 2 Trophs MP.jpg (file) |  |
56 KB | Admin | 1 | |
| 12:56, 10 February 2025 | TF1e.jpg (file) |  |
44 KB | Admin | 1 | |
| 12:55, 10 February 2025 | TF1d.jpg (file) |  |
44 KB | Admin | 1 | |
| 12:54, 10 February 2025 | TF1c.jpg (file) |  |
49 KB | Admin | 1 | |
| 18:11, 9 February 2025 | TF1b.jpg (file) |  |
55 KB | Admin | 1 | |
| 11:39, 8 February 2025 | Species3.jpg (file) |  |
57 KB | Admin | 1 | |
| 21:27, 7 February 2025 | PKGanno.jpg (file) |  |
69 KB | Admin | 1 | |
| 21:27, 7 February 2025 | PKSanno.jpg (file) |  |
60 KB | Admin | 1 | |
| 21:27, 7 February 2025 | PKLTanno.jpg (file) |  |
68 KB | Admin | 1 | |
| 21:26, 7 February 2025 | PKETanno.jpg (file) |  |
65 KB | Admin | 1 | |
| 18:59, 6 February 2025 | ET Hb metabolism ESP.jpg (file) |  |
153 KB | Admin | 1 | |
| 18:43, 6 February 2025 | LifecycleESP.jpg (file) |  |
209 KB | Admin | 1 | |
| 18:01, 6 February 2025 | PMGanno.jpg (file) |  |
91 KB | Admin | 1 | |
| 17:54, 6 February 2025 | PMSanno.jpg (file) |  |
78 KB | Admin | 1 | |
| 17:54, 6 February 2025 | PMLTanno.jpg (file) |  |
72 KB | Admin | 1 | |
| 17:54, 6 February 2025 | PMETanno.jpg (file) |  |
78 KB | Admin | 1 | |
| 15:58, 5 February 2025 | MicroPM.jpg (file) |  |
46 KB | Admin | 1 | |
| 15:57, 5 February 2025 | MacroPM.jpg (file) |  |
120 KB | Admin | 1 | |
| 11:55, 17 January 2025 | Species2.jpg (file) |  |
69 KB | Admin | 2 | |
| 16:48, 9 January 2025 | POSanno.jpg (file) |  |
117 KB | Admin | 1 | |
| 16:41, 9 January 2025 | POETanno.jpg (file) |  |
93 KB | Admin | 1 | |
| 16:32, 9 January 2025 | POGanno.jpg (file) |  |
112 KB | Admin | 1 | |
| 16:31, 9 January 2025 | POGinfo.jpg (file) |  |
69 KB | Admin | 1 | |
| 16:31, 9 January 2025 | POSinfo.jpg (file) |  |
72 KB | Admin | 1 | |
| 16:30, 9 January 2025 | POLTanno.jpg (file) |  |
103 KB | Admin | 1 | |
| 16:30, 9 January 2025 | POLTinfo.jpg (file) |  |
70 KB | Admin | 1 | |
| 16:29, 9 January 2025 | POETinfo.jpg (file) |  |
60 KB | Admin | 1 | |
| 16:29, 9 January 2025 | PVGinfo.jpg (file) |  |
93 KB | Admin | 2 | |
| 13:27, 6 January 2025 | PVLTinfo.jpg (file) |  |
70 KB | Admin | 1 | |
| 13:22, 6 January 2025 | PVGanno.jpg (file) |  |
102 KB | Admin | 1 | |
| 13:22, 6 January 2025 | PVSanno.jpg (file) |  |
103 KB | Admin | 1 | |
| 13:21, 6 January 2025 | PVSinfo.jpg (file) |  |
71 KB | Admin | 1 | |
| 13:21, 6 January 2025 | PVLTanno.jpg (file) |  |
98 KB | Admin | 1 | |
| 10:49, 6 January 2025 | PVETanno.jpg (file) |  |
92 KB | Admin | 1 | |
| 10:48, 6 January 2025 | PVETinfo.jpg (file) |  |
69 KB | Admin | 1 | |
| 13:16, 5 January 2025 | PFGinfo.jpg (file) |  |
53 KB | Admin | 1 | |
| 13:05, 5 January 2025 | PFSinfo.jpg (file) |  |
49 KB | Admin | 1 | |
| 13:05, 5 January 2025 | PFSanno.jpg (file) |  |
68 KB | Admin | 2 | |
| 21:31, 4 January 2025 | PFLTanno.jpg (file) |  |
62 KB | Admin | 1 | |
| 21:31, 4 January 2025 | PFLTinfo.jpg (file) |  |
44 KB | Admin | 1 | |
| 20:40, 2 January 2025 | PFETc.jpg (file) |  |
197 KB | Admin | 3 | |
| 20:40, 2 January 2025 | PFETanno.jpg (file) |  |
213 KB | Admin | 1 | |
| 20:31, 2 January 2025 | PFET3mag.jpg (file) | |
79 KB | Admin | 1 | |
| 20:30, 2 January 2025 | PFETinfo.jpg (file) |  |
201 KB | Admin | 1 |